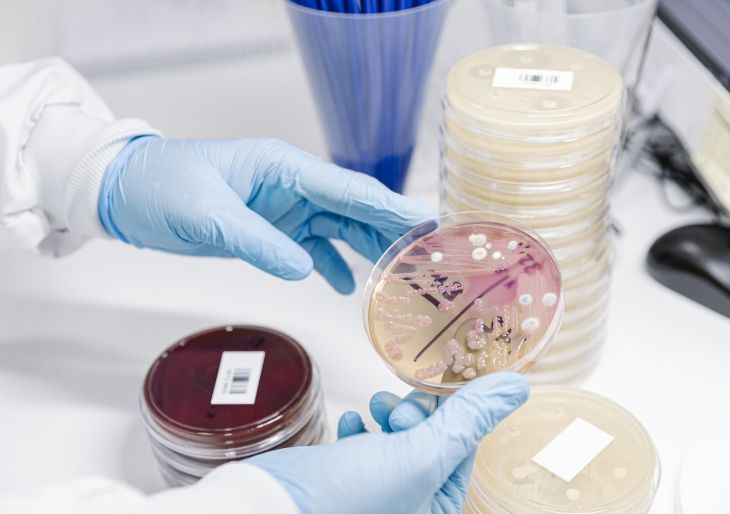

Thinking of fungi probably conjures up an image of some wild mushrooms or a sourdough starter in your mind. That, or maybe a time where you had an unfortunate itchy skin rash that went away with a bit of topical medication.
But researchers in mycology – the study of fungi – have long warned that fungi can have a much more sinister side. While we’re unlikely to see a pandemic play out – certainly not along the lines of scenarios portrayed in fictional TV series The Last of Us – real-life scientists are worried about rising rates and severity of fungal infections worldwide.
“Fungi have historically been overlooked in infectious disease research,” says Dr Megan Lenardon, a microbiologist and a senior lecturer in UNSW’s School of Biotechnology and Biomolecular Sciences. “There are many pathogens with different transmission routes and many challenges with therapies and diagnostics.”
An emerging fungal threat
The threat of fungal pathogens is now gaining worldwide attention from public health bodies. The World Health Organization recently released its first-ever watchlist of fungal priority pathogens – species of highest concern that require serious attention.
Dr Lenardon has been studying the cell and molecular biology of Candida albicans, which was identified as one of the four fungi of critical priority. Candida species cause non-serious infections like thrush in tens of millions of people per year. But of more concern are the 700,000 invasive infections that can kill people, about half of which are caused by C. albicans.
“We call them ‘opportunistic invasive’ fungal pathogens because they don’t kill healthy people,” Dr Lenardon says. “But if they find themselves in a host who is susceptible, then they can kill.”
Some fungi, like Aspergillus and Cryptococcus, are breathed in through spores that exist everywhere in the environment but are usually no match for our immune systems. Others, like C. albicans, colonise the gut of healthy individuals, but the physical barrier between the bloodstream, gut microbiota and a firing immune system is generally enough to prevent infections.
But when these defences are compromised, it can leave us vulnerable to infection. In immunocompromised people, C. albicans can escape the gut, circulate throughout the blood, and invade organs.
“Serious fungal infections are more of a risk for people with underlying health conditions,” Dr Lenardon says. “People with cancer or HIV/AIDS, organ transplant recipients, and intensive care patients are among those who are more vulnerable to infection.”
While the likelihood of acquiring a severe fungal infection is rare, infection is often deadly. At least 40 per cent of systemic C. albicans infections are fatal despite the availability of antifungals. By comparison, a nasty bacterial infection like Staphylococcus aureus (golden staph) kills in around 25 per cent of cases.
According to new estimates, there are 6.5 million invasive infections and 3.8 million deaths globally each year associated with severe fungal disease.
“The number of deaths from fungal infections is also likely underreported,” Dr Lenardon says. “Usually, an existing health condition is recorded as the cause of death when the fungal infection was responsible.”

40 per cent of systemic C. albicans infections are fatal despite the availability of antifungal medication. Photo: Getty Images.
Resistance to antifungal treatment
Like antibiotic resistance, there is also increasing worry over antifungal resistance. Overusing and misusing antifungal medications in agriculture and healthcare settings can develop resistant strains, making infections harder to treat.
“When Candida auris first emerged in healthcare settings in the late 2000s, it was already drug-resistant,” Dr Lenardon says. “We’re seeing more and more resistance in the clinic to existing antifungal treatments, so antifungal stewardship is crucial.”
Serious fungal infections can also be difficult for medical practitioners to diagnose. Symptoms can vary drastically between fungus types and often present just like bacterial infections.
“So, time to diagnosis is a problem, and there aren’t a lot of specialist clinical mycologists,” Dr Lenardon says.
Another problem is the few drugs available to treat serious fungal infections. There are only five classes of antifungal medications for use in clinical settings – that’s compared to at least 38 classes of antibiotics to treat bacterial infections. Some of these antifungal treatments also inadvertently target human cells, while others aren’t very effective.
“Fungi are biologically very similar to us, so there are very few differences between fungal cells and human cells that we can exploit in therapy,” Dr Lenardon says. “The things that we do exploit are sometimes quite toxic to us because they target not only fungal cell membranes but human cell membranes too.”
Developing new fungal treatments remains a challenge. Among infectious disease research, mycology is also a relatively small field and receives just a fraction of funding compared to bacteria, viruses and parasites. Few preventative treatments are in the drug pipeline, and no vaccines are imminent.
The likelihood of future fungal pandemics
Despite this, Dr Lenardon says we’re unlikely to see a fungi outbreak sweep through humans at this stage. One reason is because most serious (life threatening) fungal pathogens that affect people are generally not transmissible from human to human.
However, some contagious fungal infections occur in other animal species, such as white-nose syndrome caused by the fungus Pseudogymnoascus destructans, which decimates bat populations. Still, no deadly fungal pathogens have been known to jump the species barrier from animals to humans.
“Even though no fungi right now are likely to cause a pandemic like COVID-19, we shouldn’t be complacent,” Dr Lenardon says. “Emerging fungal diseases still pose a significant risk, especially as the number of people at risk of infection is expected to grow.”
Read more: How a lethal fungus is shrinking living space for our frogs
In other good news, most fungal species also can’t survive at the temperature of the human body. However, there are some fears that as the world continues to heat up from climate change, some may be able to adapt to overcome the temperature barrier.
“Fungi may evolve to resist higher temperatures, which means we might see the emergence of a species that can survive in our bodies,” Dr Lenardon says. “The overall risk of a pandemic, though, is probably still relatively low, and these pathogens would still have to get past our immune systems.”
But Dr Lenardon says we’re underprepared to deal with a fungal pandemic should one break out tomorrow. More coordinated research is needed to stay on top of emerging threats, which requires more investment.
“Strengthening surveillance networks is critical to identifying any potential fungal threats before they arise,” Dr Lenardon says. “We also desperately need more funding to address the urgent clinical need for better diagnostics and new therapies.”